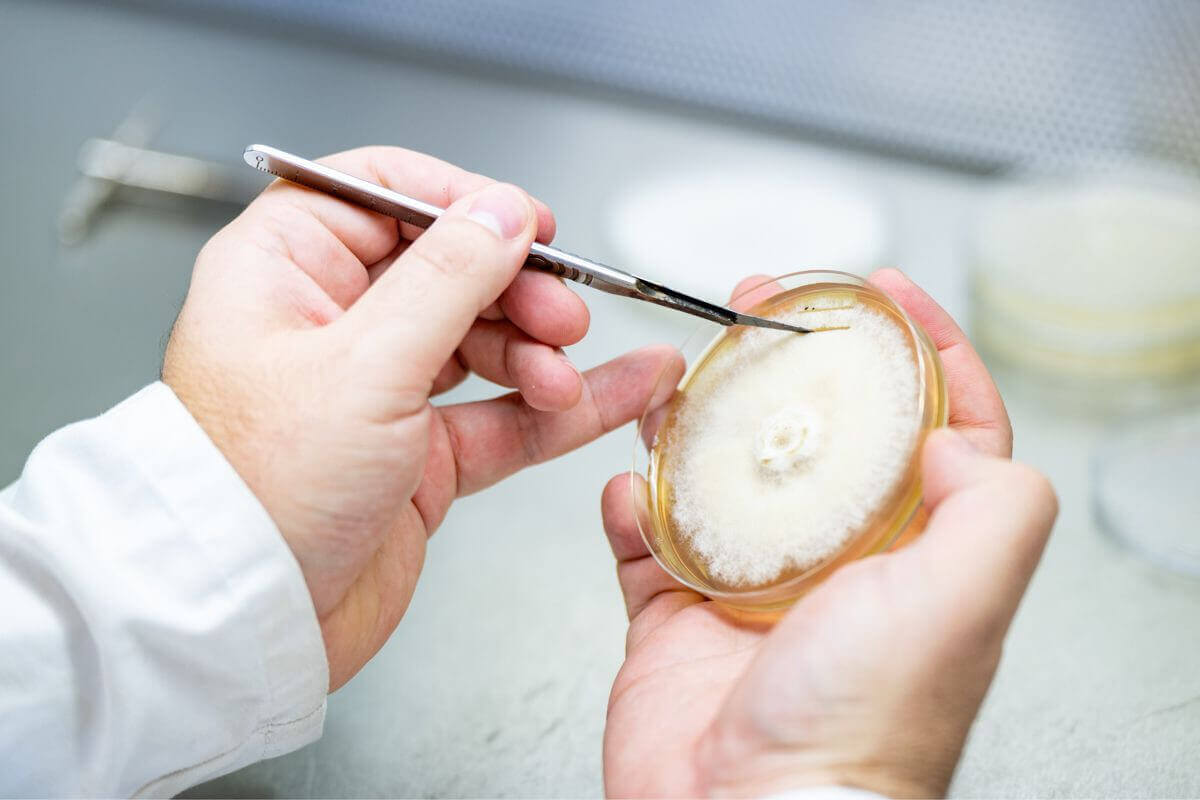

In its January 7th edition, the business monthly La Lettre M highlights our development strategy and the creation of a spin-off dedicated to commercializing soil biodiversity regeneration solutions.
After 5 years of R&D within MYCEA, the soil biodiversity regeneration activity through amplification of native mycorrhizal fungi from each terroir is giving birth to Amoterra, a company dedicated to its commercialization.
This achievement of our strategy is a strong signal of the scalability of our solutions.
The ag-biotech company MYCEA is now focused exclusively on its other activity: exploring the biological and biochemical properties of forest fungi for plant health.
Key points from the La Lettre M article about MYCEA:
Differentiation: MYCEA has 750 tested forest fungal strains and 2,000 active extracts effective against 20+ crop diseases. The two current candidates target diseases severely impacted by a lack of treatment solutions due to active substance bans or resistance development.
Industrialization: ARD is MYCEA’s partner for production scale-up. A first 8,000-liter scale-up has already been successfully completed, and a second is underway.
Partnerships: “We also want to establish partnerships with industrial players to partner with for commercialization,” says Aline Bsaibes, Business CEO of MYCEA.